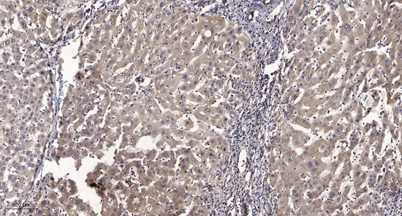

$148.00/50µL $248.00/100µL
| 50 µL | $148.00 |
| 100 µL | $248.00 |
| Product name: | RITA rabbit pAb |
| Reactivity: | Human; Mouse;Rat |
| Source: | Rabbit |
| Dilutions: | WB 1:500-2000;IHC-p 1:50-300 |
| Immunogen: | Synthesized peptide derived from human RITA AA range: 213-263 |
| Storage: | -20°C/1 year |
| Clonality: | Polyclonal |
| Isotype: | IgG |
| Concentration: | 1 mg/ml |
| Molecular Weight: | 30kD |
| GeneID: | 84934 |
| Human Swiss-Prot No: | Q96K30 |
| Cellular localization: | Cytoplasm . Nucleus . Cytoplasm, cytoskeleton, microtubule organizing center, centrosome . Shuttles rapidly between the cytoplasm and the nucleus. The function of centrosome localization is still unclear. |